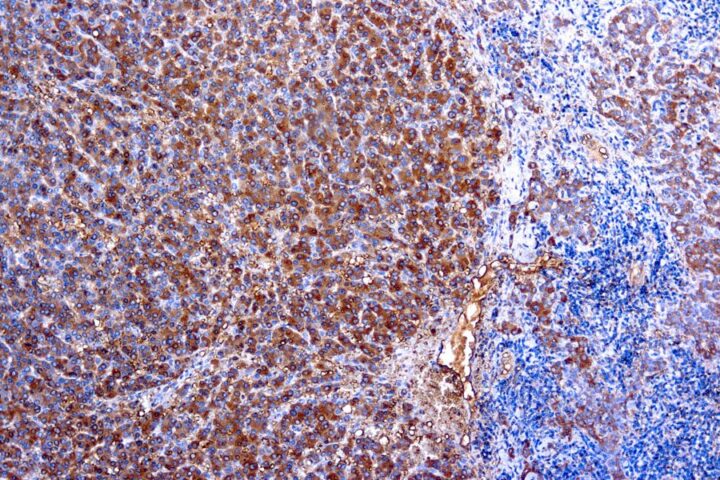
Immunohistochemical staining of alpha-1-Antitrypsin  of human FFPE tissue followed by incubation with HRP labeled secondary and development with DAB substrate.

alpha-1-Antitrypsin [Polyclonal] Antibody (cGMP).
SKU: QIVD213
Species: Human
Tested Applications: IHC [IVD]
Available Conjugates:
Isotype: Rabbit Undetermined
Species: Human
Tested Applications: IHC [IVD]
Available Conjugates:
Isotype: Rabbit Undetermined